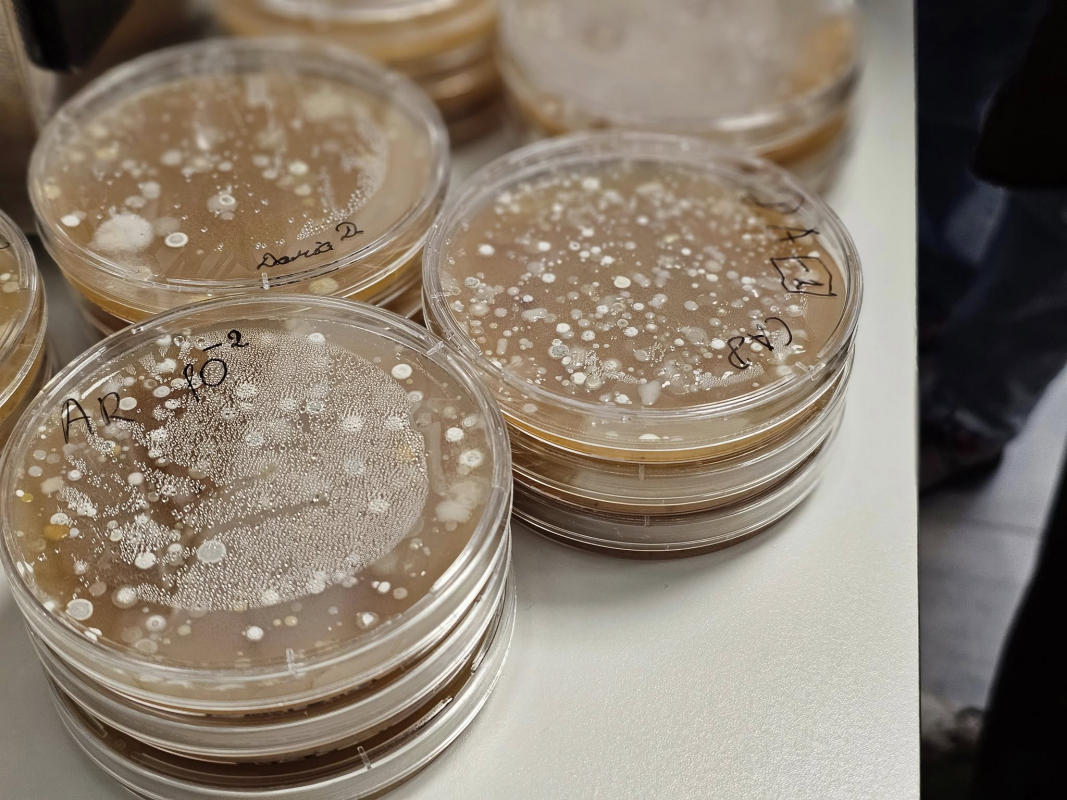
Фото з Літньої школи
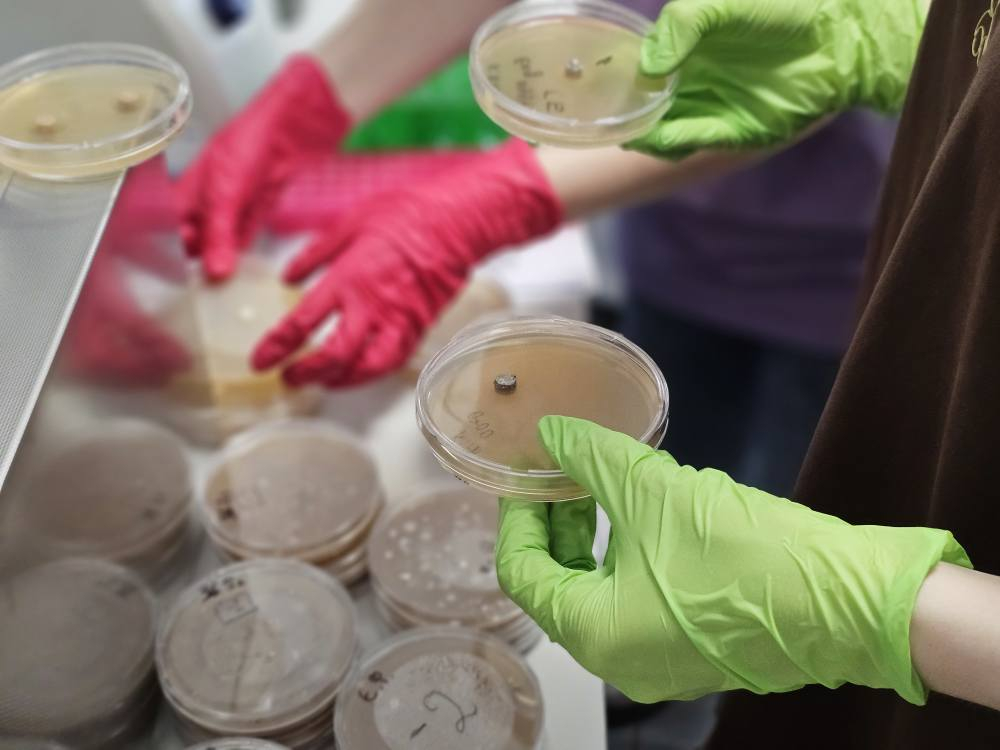
Фото з Літньої школи
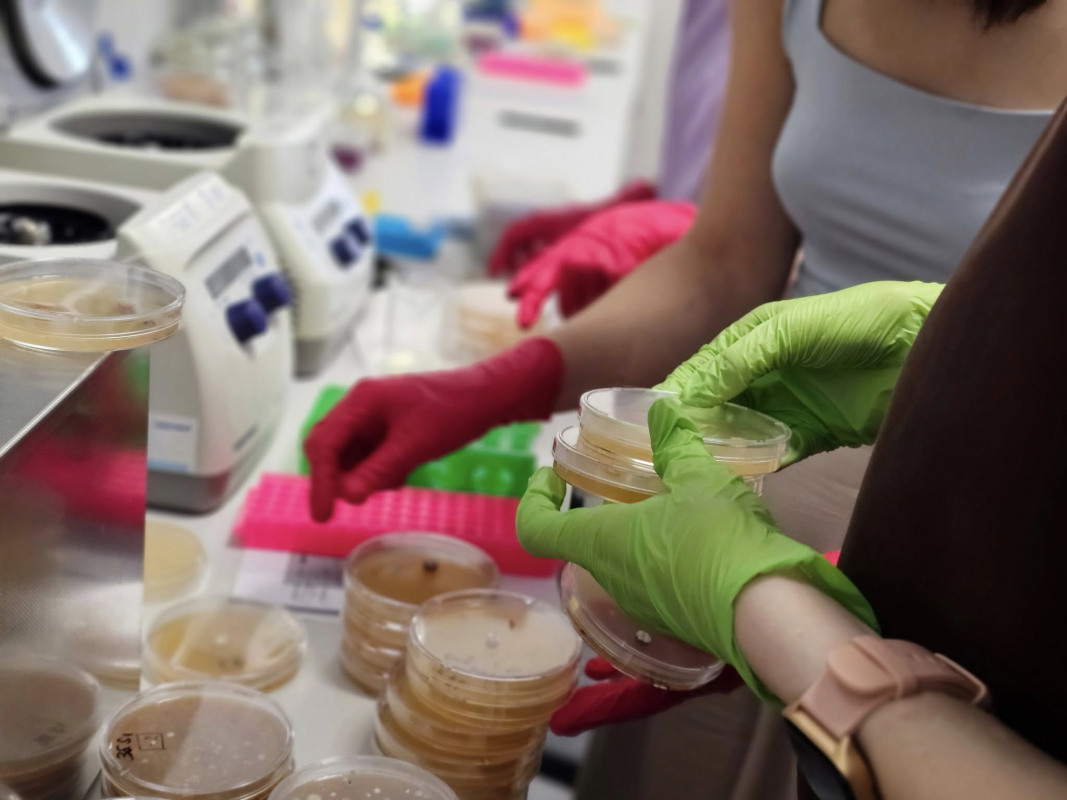
Фото з Літньої школи

Студентка магістратури освітньо-наукової програми спеціальності «Біотехнології та біоінженерія» групи БТМ-21 кафедри технології біологічно активних сполук, фармації та біотехнології Інституту хімії та хімічних технологій Львівської політехніки Ангеліна Домашовець взяла участь у Літній школі з дослідження природних сполук 2025 року.
З 25 по 31 серпня учасники школи:
- вчилися виділяти актинобактерії зі зразків ґрунту;
- досліджували гетерологічну експресію BGC;
- аналізували дані LC-MS та геномні датасети;
- проводили практичні роботи із клонування генів, міжродової кон’югації та виділення ДНК.
Ангеліна відзначила чудову організацію школи, структуровану програму та натхненну атмосферу, яку створювали наставники та учасники. Особливо цінним для неї стало поєднання теорії з практикою: клонування генів, виділення геномної та плазмідної ДНК, екстракція метаболітів та перевірка їхньої біоактивності. Велику роль у цьому досвіді відіграли ментори, які щедро ділилися своїми знаннями та порадами, заснованими на власних наукових досягненнях.
Не менш важливою частиною події стала подорож у Карпати, яка подарувала Ангеліні нових друзів, теплу атмосферу спілкування та натхнення для майбутніх досліджень.
На кафедрі ТБСФБ пишаються Ангеліною та впевнені, що цей досвід стане чудовим поштовхом для її майбутніх досліджень і кар’єрного зростання.
Подія стала можливою завдяки підтримці та співпраці Університету Саарланду (Universität des Saarlandes), Інституту фармацевтичних досліджень Гельмгольца в Саарланді (HIPS), Львівського національного університету імені Івана Франка та Explogen LLC.